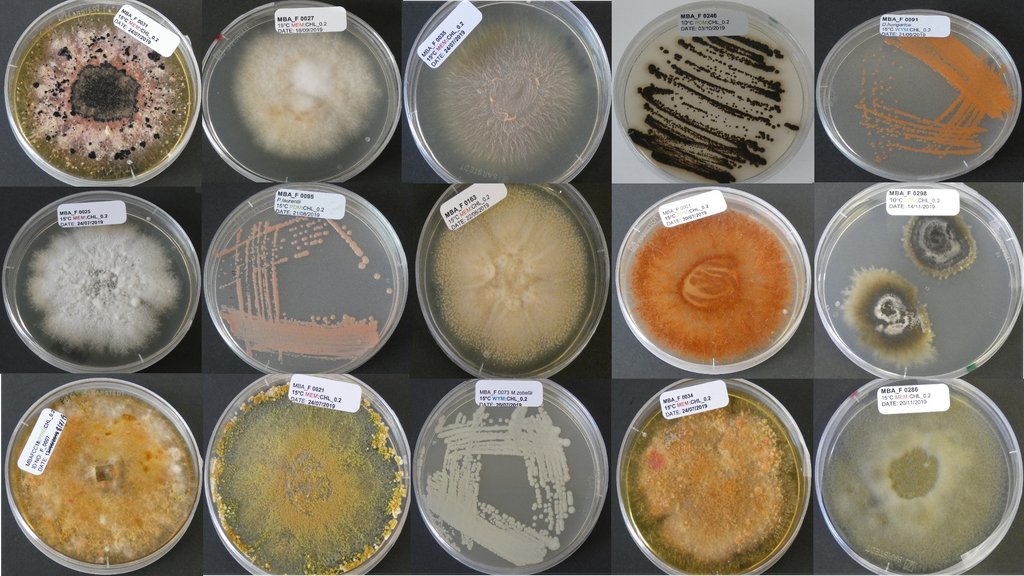
MBA - Marine Biological Association tweet media

@Amy_Gray_1 @young_isdr @vivjones2 @Hannaea_Fossil @TomCBHill @DiatomsATTACK Metascolioneis tumida possibly. Brackish species
English
Angela Ward
94 posts

@AngelaBirdBrain
Marine Biologist. Loves all things bird and algae.

































It's with great sadness that we say goodbye to Jack Dickenson @JED_Science as he moves onto pastures new! Good luck! You'll be missed! Slightly unconventional goodbye ceremony in the car park with an amazing PhD hat made by @Kimberley_EBird and @birthe_z @thembauk